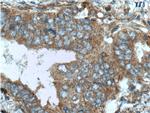
ILK Antibody in Immunohistochemistry (Paraffin) (IHC (P))

Search
Proteintech
ILK Polyclonal Antibody
{{$productOrderCtrl.translations['antibody.pdp.commerceCard.promotion.promotions']}}
{{$productOrderCtrl.translations['antibody.pdp.commerceCard.promotion.viewpromo']}}
{{$productOrderCtrl.translations['antibody.pdp.commerceCard.promotion.promocode']}}: {{promo.promoCode}} {{promo.promoTitle}} {{promo.promoDescription}}. {{$productOrderCtrl.translations['antibody.pdp.commerceCard.promotion.learnmore']}}
产品信息
24926-1-AP
种属反应
宿主/亚型
分类
类型
抗原
偶联物
形式
浓度
规格
纯化类型
保存液
内含物
保存条件
运输条件
产品详细信息
Immunogen sequence: MDDIFTQCR EGNAVAVRLW LDNTENDLNQ GDDHGFSPLH WACREGRSAV VEMLIMRGAR INVMNRGDDT PLHLAASHGH RDIVQKLLQY KADINAVNEH GNVPLHYACF WGQDQVAEDL VANGALVSIC NKYGEMPVDK AKAPLRELLR ERAEKMGQNL NRIPYKDTFW KGTTRTRPRN GTLNKHSGID FKQLNFLTKL NENHSGELWK GRWQGNDIVV KVLKVRDWST RKSRDFNEEC PRLRIFSHPN VLPVLGACQS PPAPHPTLIT HWMPYGSLYN VLHEGTNFVV DQSQAVKFAL DMARGMAFLH TLEPLIPRHA LNSRSVMIDE DMTARISMAD VKFSFQCPGR MYAPAWVAPE ALQKKPEDTN RRSADMWSFA VLLWELVTRE VPFADLSNME IGMKVALEGL RPTIPPGISP HVCKLMKICM NEDPAKRPKF DMIVPILEKM QDK (1-452 aa encoded by BC001554)
靶标信息
Transduction of extracellular matrix signals through integrins influences intracellular and extracellular functions, and appears to require interaction of integrin cytoplasmic domains with cellular proteins. Integrin-linked kinase (ILK), interacts with the cytoplasmic domain of beta-1 integrin. This gene encodes a serine/threonine protein kinase with 4 ankyrin-like repeats, which associates with the cytoplasmic domain of beta integrins and acts as a proximal receptor kinase regulating integrin-mediated signal transduction. Multiple alternatively spliced transcript variants encoding the same protein have been found for this gene.
仅用于科研。不用于诊断过程。未经明确授权不得转售。
生物信息学
蛋白别名: 59 kDa serine/threonine-protein kinase; beta-integrin-linked kinase; epididymis secretory protein Li 28; ILK; ILK-1; ILK-2; Inactive integrin-linked kinase; integrin binding protein kinase; Integrin linked ILK; integrin-linked kinase-2; integrin-linked protein kinase; p59ILK; Scaffold protein ILK; unnamed protein product
基因别名: AA511515; ESTM24; HEL-S-28; ILK; ILK-1; ILK-2; ILK1; ILK2; P59; p59ILK
UniProt ID: (Human) Q13418, (Mouse) O55222
Entrez Gene ID: (Human) 3611, (Mouse) 16202